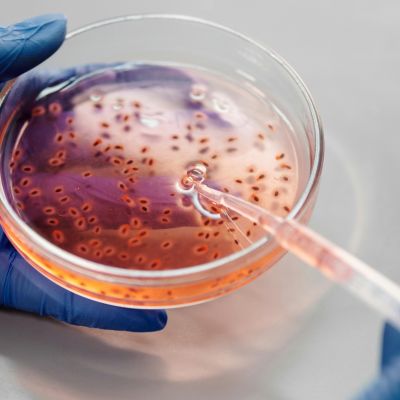
Photo of a teat pipette taking a sample from a petri dish

Food Technology and Processing
Learn about our theme

- Faculty of Environment
- School of Food Science and Nutrition
Food technology and Processing
We are pioneering smart technologies for deep process understanding to enhance food quality, support healthier production, and promote sustainability across the supply chain.
Next-generation food manufacturing requires advanced engineering and smart technologies to precisely control organoleptic, physicochemical, and nutritional qualities while ensuring safety.
Our sub themes

Food Engineering and Processing
This theme focuses on advancing innovative process monitoring technologies to enhance the nutritional value and appeal of food. We prioritise sustainable ingredients and alternative processing methods to develop protein-, lipid-, and fibre-rich foods for future generations. In collaboration with global industry partners, we conduct full life cycle impact analyses to address real-world challenges in next-generation food manufacturing.
Fermentation and Biotechnology
In response to the global demand for sustainable food systems, this theme promotes fermentation and biotechnological approaches to create novel food products. By precisely controlling cellular processes, we enable the sustainable production of biomass and high-value ingredients, offering alternatives to traditional agricultural methods.
Our people
Our research academics and staff—including research fellows, research associates, and research assistants— all play a vital role in supporting and developing our work in Food Technology and Processing.
Learn more about them and their work and projects.


